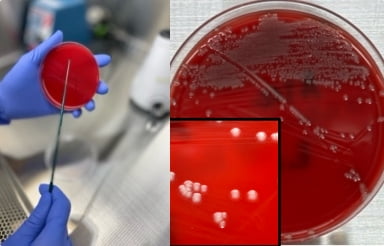

検査室紹介
Laboratory
感染症検査部門
感染症検査部門では、細菌や真菌の分離・同定および薬剤感受性試験を行う微生物検査、PCRなどの核酸増幅法を用いて病原体遺伝子を検出する遺伝子検査、さらに(1→3)-β-D-グルカンやエンドトキシンの測定といった感染症に関連する検査を実施しています。
1. 微生物検査
塗抹検査



検体をスライドガラスに塗布してグラム染色後、顕微鏡にて観察します。
細菌の推測や炎症の程度を把握することができます
培養・同定検査

検体を培地に塗布し、適した温度で培養を行うと、24~48時間にコロニー(集落)を形成します。
同定検査ではコロニーを用いて質量分析装置や生化学性状にて菌名を決定します。

薬剤感受性検査
細菌の種類によって効果がある薬剤は様々です。薬剤感受性検査では同定した菌に効果が有るか無いかを判定します。
また、検査だけでなく院内感染対策チーム(ICT)、抗菌薬適正使用支援チーム(AST)の一員として薬剤耐性菌の動向提供や病棟ラウンドを実施し感染対策にも取り組んでいます。

血液培養検査
血液培養自動分析装置 BD バクテック™ FX システム
患者さんから採取した血液を専用の培養ボトルに接種し、培養することで、血液中に細菌が存在するかどうかを調べます。
2. 遺伝子検査

全自動遺伝子解析装置 FilmArray® システム
核酸抽出・PCR増幅・検出までを自動で行い、一回の測定で2種類以上の遺伝子配列を増幅し、ウイルスや細菌を検出します。

自動遺伝子解析装置 GeneXpert® システム
核酸抽出・PCR増幅・検出までを自動で行い、感染症を迅速に検査することができます。

cobas® 5800 システム
核酸の抽出からPCRによる増幅・検出までをすべて自動で行い、複数の感染症を同時に検査することができます。
3. 感染症関連検査

微生物由来成分分析装置 トキシノメーター MT-6500
血液中のエンドトキシンや(1→3)-β-D-グルカンを測定する装置です。細菌や真菌による感染症の検査に用いられ、迅速かつ高感度な検出が可能です。
